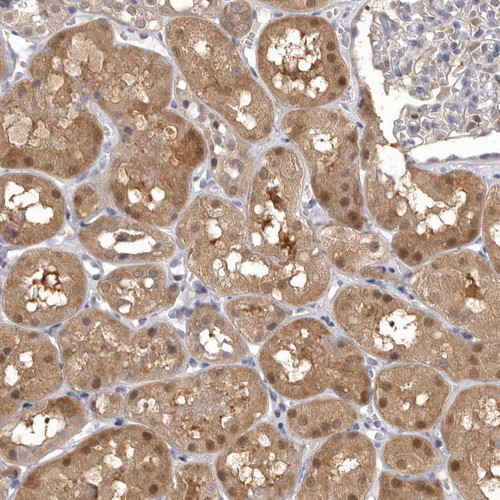

Cosmo Bio USA provides a broad portfolio of metabolism research products designed to support studies across the key pathways that drive cellular energy production and biosynthesis. The catalog includes validated antibodies, ELISA kits, and recombinant proteins for enzymes regulating glycolysis, the TCA cycle, and gluconeogenesis, including hexokinase, phosphofructokinase, pyruvate kinase, lactate dehydrogenase, pyruvate dehydrogenase, citrate synthase, and multiple isoforms of isocitrate and malate dehydrogenases. These tools enable researchers to follow metabolic flux from glucose uptake through mitochondrial respiration, providing valuable insights into normal physiology as well as pathological contexts such as cancer metabolism, diabetes, and other metabolic disorders. Complementary products extend into lipid pathways, with reagents for key regulators of fatty acid synthesis, mitochondrial transport, and β-oxidation, supporting detailed investigations into lipid utilization and energy homeostasis.
Beyond carbohydrate and lipid metabolism, the portfolio supports research into amino acid metabolism, nucleotide synthesis, and redox balance. Products targeting enzymes of glutamine, serine, glycine, and branched-chain amino acid pathways allow precise monitoring of nutrient processing, nitrogen balance, and anabolic regulation. Tools for nucleotide biosynthesis and salvage provide a window into DNA and RNA production, cell cycle control, and replication fidelity, while reagents for redox-related enzymes enable exploration of NAD+/NADH balance, oxidative stress responses, and antioxidant defenses. Together, this portfolio offers a technically comprehensive foundation for studying the enzymatic and molecular networks that sustain cellular metabolism. By integrating rigorously validated antibodies, recombinant proteins, and assay kits, Cosmo Bio USA equips researchers with the tools needed to advance discovery in biochemistry, oncology, metabolic disease, and therapeutic development.
Explore the complete portfolio of reagents for metabolism research below.